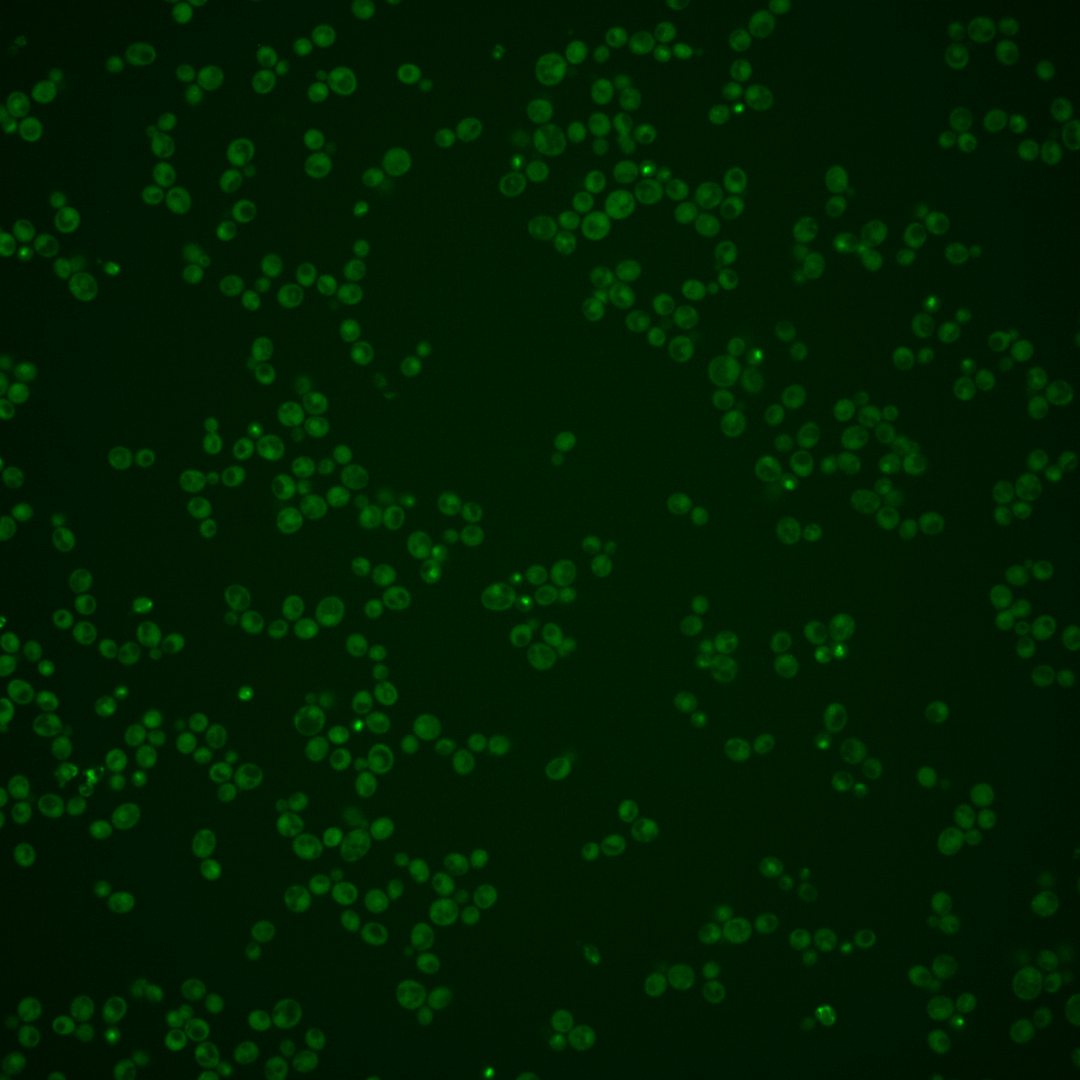
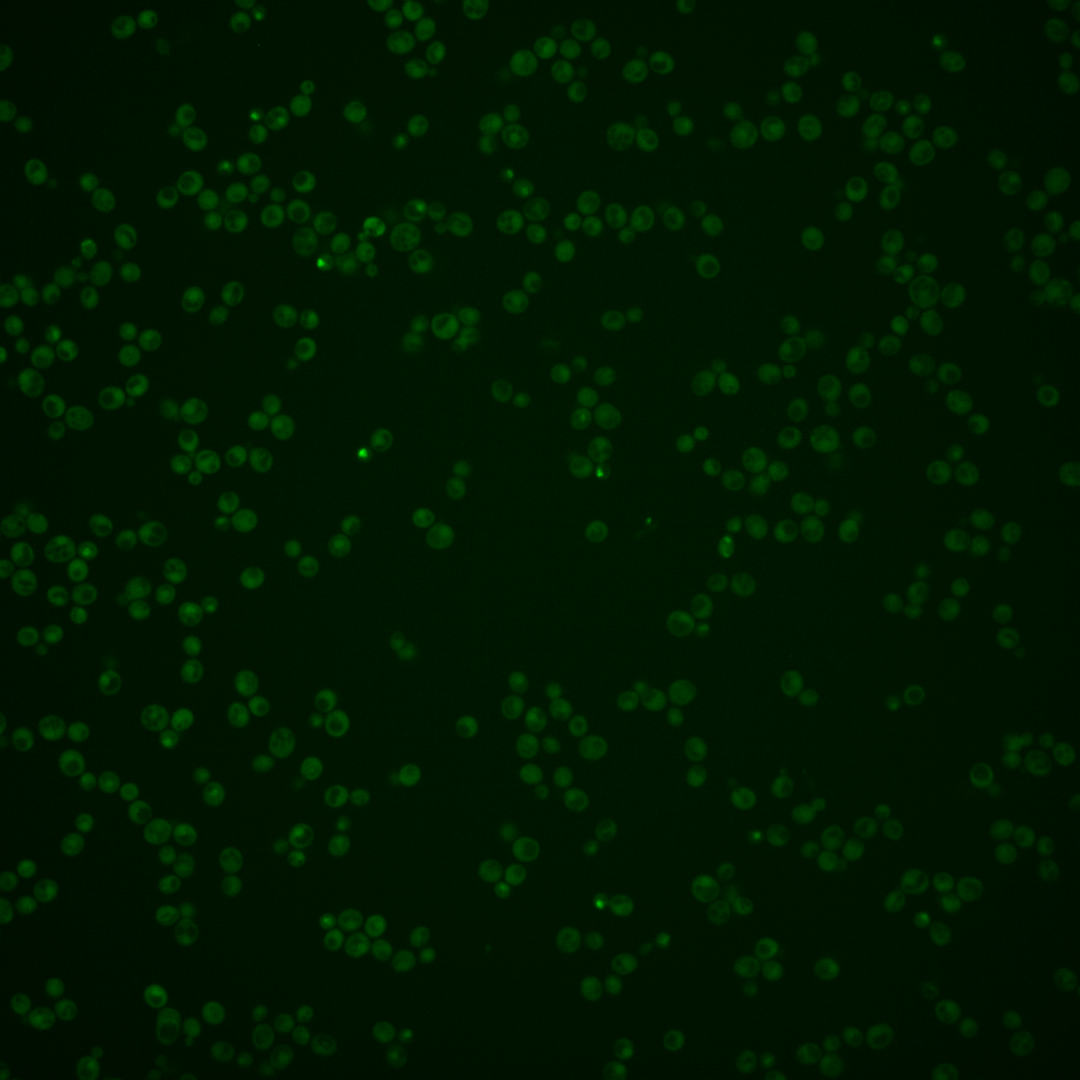
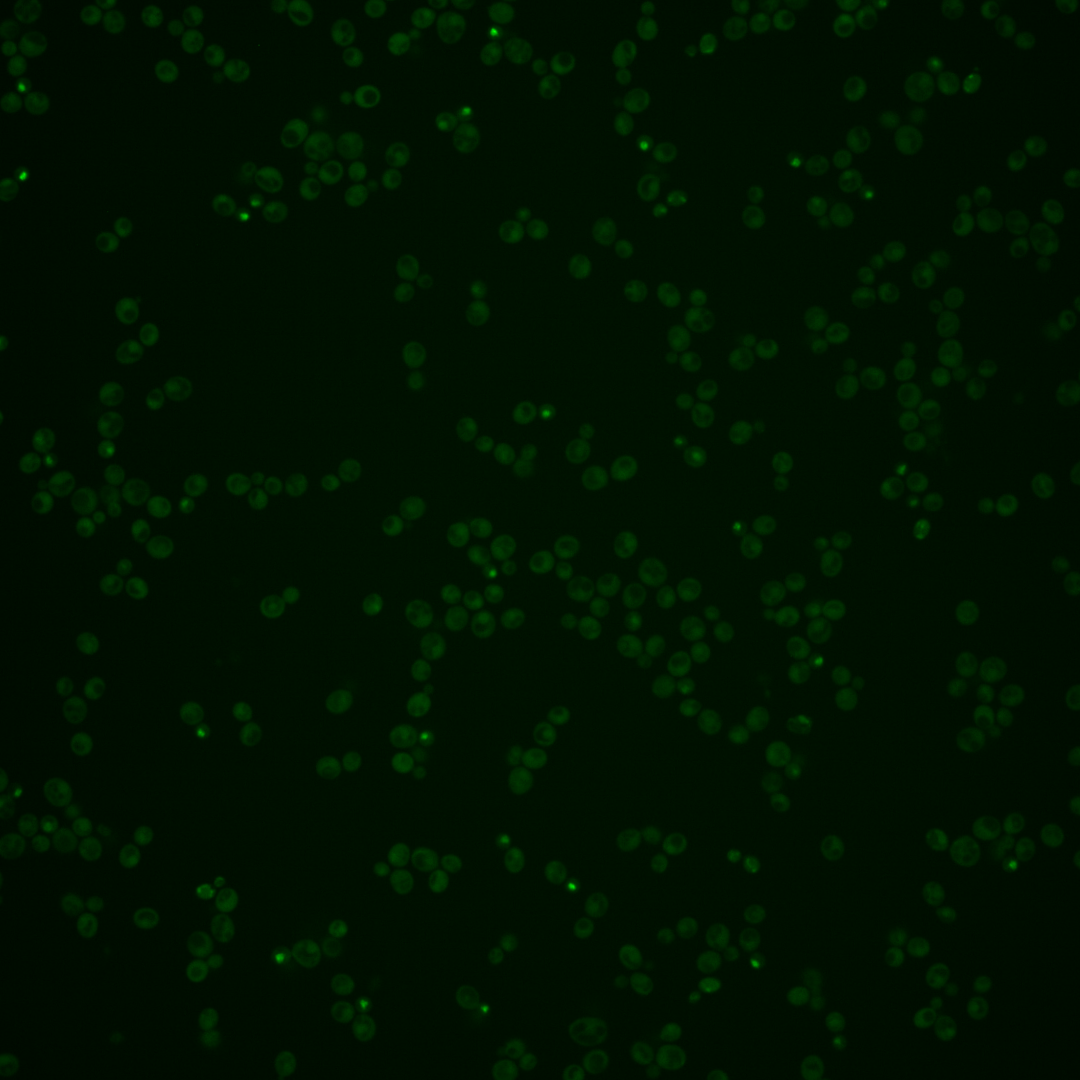

| Standard name | |
|---|---|
| Human Ortholog | |
| Description | Transcription factor required for septum destruction after cytokinesis; phosphorylation by Cbk1p blocks nuclear exit during M/G1 transition, causing localization to daughter cell nuclei, and also increases Ace2p activity; phosphorylation by Cdc28p and Pho85p prevents nuclear import during cell cycle phases other than cytokinesis; part of RAM network that regulates cellular polarity and morphogenesis; ACE2 has a paralog, SWI5, that arose from the whole genome duplication |
Micrographs




















































































Sub-cellular Localization
Yeast GFP Assignment
Protein Abundance
Localization Change
External localization resources
| ensLOC | DeepLoc | |||||||||||||||||||||||
|---|---|---|---|---|---|---|---|---|---|---|---|---|---|---|---|---|---|---|---|---|---|---|---|---|
| Localization | WT1 | WT2 | WT3 | RAP60 | RAP140 | RAP220 | RAP300 | RAP380 | RAP460 | RAP540 | RAP620 | RAP700 | HU80 | HU120 | HU160 | rpd3Δ_1 | rpd3Δ_2 | rpd3Δ_3 | WT1 | WT2 | WT3 | AF100 | AF140 | AF180 |
| Cortical Patches | 0 | 0 | 0 | 0 | 0 | 0 | 1 | 1 | 0 | – | 0 | 0 | 0 | 0 | 0 | 0 | 0 | 0 | 2 | 1 | 0 | 0 | 4 | 4 |
| Bud | 1 | 3 | 1 | 0 | 1 | 2 | 4 | 4 | 4 | – | 0 | 6 | 1 | 0 | 0 | 1 | 2 | 1 | 23 | 16 | 7 | 13 | 27 | 20 |
| Bud Neck | 2 | 0 | 0 | 0 | 1 | 1 | 2 | 5 | 5 | – | 1 | 1 | 0 | 0 | 0 | 0 | 0 | 0 | 1 | 3 | 0 | 1 | 4 | 2 |
| Bud Site | 0 | 0 | 0 | 0 | 0 | 0 | 0 | 0 | 0 | – | 0 | 0 | 0 | 0 | 0 | 0 | 0 | 0 | – | – | – | – | – | – |
| Cell Periphery | 0 | 0 | 0 | 0 | 1 | 0 | 0 | 1 | 0 | – | 0 | 0 | 0 | 1 | 0 | 10 | 14 | 5 | 1 | 1 | 0 | 0 | 1 | 1 |
| Cytoplasm | 300 | 176 | 74 | 64 | 59 | 85 | 98 | 162 | 111 | – | 47 | 85 | 229 | 266 | 291 | 223 | 140 | 166 | 248 | 139 | 62 | 32 | 95 | 89 |
| Endoplasmic Reticulum | 0 | 0 | 0 | 0 | 1 | 0 | 2 | 0 | 0 | – | 0 | 0 | 2 | 0 | 2 | 16 | 9 | 6 | 0 | 0 | 0 | 1 | 2 | 0 |
| Endosome | 4 | 6 | 1 | 0 | 0 | 0 | 0 | 0 | 1 | – | 0 | 0 | 0 | 0 | 0 | 5 | 2 | 6 | 5 | 3 | 0 | 3 | 5 | 5 |
| Golgi | 0 | 0 | 0 | 0 | 0 | 0 | 0 | 0 | 0 | – | 0 | 0 | 0 | 0 | 0 | 3 | 2 | 1 | 1 | 0 | 0 | 0 | 0 | 0 |
| Mitochondria | 7 | 4 | 4 | 5 | 1 | 14 | 26 | 25 | 49 | – | 21 | 43 | 2 | 0 | 2 | 7 | 6 | 3 | 3 | 4 | 3 | 3 | 11 | 4 |
| Nucleus | 20 | 11 | 13 | 1 | 3 | 7 | 9 | 13 | 8 | – | 1 | 6 | 0 | 1 | 0 | 11 | 15 | 7 | 21 | 13 | 11 | 4 | 10 | 5 |
| Nuclear Periphery | 0 | 0 | 0 | 0 | 0 | 1 | 0 | 0 | 0 | – | 0 | 0 | 0 | 0 | 0 | 0 | 0 | 1 | 0 | 0 | 0 | 0 | 0 | 0 |
| Nucleolus | 1 | 4 | 3 | 1 | 0 | 2 | 3 | 2 | 2 | – | 1 | 0 | 1 | 0 | 0 | 6 | 3 | 2 | 9 | 5 | 2 | 3 | 6 | 4 |
| Peroxisomes | 0 | 0 | 0 | 0 | 0 | 0 | 0 | 0 | 0 | – | 0 | 0 | 0 | 0 | 0 | 0 | 1 | 0 | 0 | 0 | 0 | 0 | 0 | 0 |
| SpindlePole | 2 | 0 | 2 | 0 | 0 | 0 | 1 | 2 | 0 | – | 0 | 1 | 0 | 0 | 0 | 0 | 1 | 1 | 26 | 20 | 11 | 6 | 23 | 9 |
| Vac/Vac Membrane | 11 | 10 | 2 | 0 | 0 | 1 | 1 | 1 | 3 | – | 0 | 4 | 0 | 2 | 3 | 29 | 16 | 18 | 5 | 3 | 3 | 11 | 17 | 18 |
| Unique Cell Count | 339 | 205 | 93 | 68 | 64 | 99 | 121 | 194 | 142 | 59 | 119 | 235 | 268 | 296 | 266 | 175 | 196 | 356 | 217 | 106 | 86 | 220 | 173 | |
| Labelled Cell Count | 348 | 214 | 100 | 71 | 67 | 113 | 147 | 216 | 183 | 71 | 146 | 235 | 270 | 298 | 311 | 211 | 217 | 356 | 217 | 106 | 86 | 220 | 173 | |
Yeast GFP Assignment
Protein Abundance
| Screen | WT1 | WT2 | WT3 | RAP60 | RAP140 | RAP220 | RAP300 | RAP380 | RAP460 | RAP540 | RAP620 | RAP700 | HU80 | HU120 | HU160 | rpd3Δ_1 | rpd3Δ_2 | rpd3Δ_3 | AF100 | AF140 | AF180 |
|---|---|---|---|---|---|---|---|---|---|---|---|---|---|---|---|---|---|---|---|---|---|
| Mean Cell GFP Intensity (1e-4) | 4.9 | 5.1 | 4.7 | 4.3 | 5.1 | 3.8 | 4.0 | 4.2 | 3.5 | – | 3.4 | 3.5 | 4.5 | 4.9 | 4.8 | 8.3 | 8.6 | 8.4 | 4.9 | 4.8 | 5.3 |
| Std Deviation (1e-4) | 0.9 | 1.1 | 0.8 | 0.9 | 1.2 | 0.8 | 1.1 | 1.1 | 0.5 | – | 1.0 | 0.8 | 1.0 | 1.2 | 1.2 | 2.4 | 2.9 | 2.9 | 1.4 | 1.6 | 2.1 |
| Intensity Change (Log2) | – | – | – | -0.13 | 0.12 | -0.3 | -0.23 | -0.16 | -0.44 | – | -0.5 | -0.42 | -0.06 | 0.06 | 0.03 | 0.82 | 0.87 | 0.83 | 0.04 | 0.02 | 0.16 |
Localization Change
| Localization | RAP60 | RAP140 | RAP220 | RAP300 | RAP380 | RAP460 | RAP540 | RAP620 | RAP700 | HU80 | HU120 | HU160 | rpd3Δ_1 | rpd3Δ_2 | rpd3Δ_3 |
|---|---|---|---|---|---|---|---|---|---|---|---|---|---|---|---|
| Cortical Patches | 0 | 0 | 0 | 0 | 0 | 0 | – | 0 | 0 | 0 | 0 | 0 | 0 | 0 | 0 |
| Bud | 0 | 0 | 0 | 0 | 0 | 0 | – | 0 | 0 | 0 | 0 | 0 | 0 | 0 | 0 |
| Bud Neck | 0 | 0 | 0 | 0 | 0 | 0 | – | 0 | 0 | 0 | 0 | 0 | 0 | 0 | 0 |
| Bud Site | 0 | 0 | 0 | 0 | 0 | 0 | – | 0 | 0 | 0 | 0 | 0 | 0 | 0 | 0 |
| Cell Periphery | 0 | 0 | 0 | 0 | 0 | 0 | – | 0 | 0 | 0 | 0 | 0 | 0 | 0 | 0 |
| Cytoplasm | 2.6 | 2.2 | 1.2 | 0.3 | 0.8 | -0.3 | – | 0 | -1.4 | 5.5 | 7.0 | 6.6 | 0.9 | 0.1 | 1.1 |
| Endoplasmic Reticulum | 0 | 0 | 0 | 0 | 0 | 0 | – | 0 | 0 | 0 | 0 | 0 | 0 | 0 | 0 |
| Endosome | 0 | 0 | 0 | 0 | 0 | 0 | – | 0 | 0 | 0 | 0 | 0 | 0 | 0 | 0 |
| Golgi | 0 | 0 | 0 | 0 | 0 | 0 | – | 0 | 0 | 0 | 0 | 0 | 0 | 0 | 0 |
| Mitochondria | 0 | 0 | 0 | 0 | 0 | 0 | – | 0 | 0 | 0 | 0 | 0 | 0 | 0 | 0 |
| Nucleus | -2.8 | -1.9 | -1.6 | -1.6 | -2.0 | -2.2 | – | -2.6 | -2.3 | 0 | 0 | 0 | -3.3 | -1.4 | -3.3 |
| Nuclear Periphery | 0 | 0 | 0 | 0 | 0 | 0 | – | 0 | 0 | 0 | 0 | 0 | 0 | 0 | 0 |
| Nucleolus | 0 | 0 | 0 | 0 | 0 | 0 | – | 0 | 0 | 0 | 0 | 0 | 0 | 0 | 0 |
| Peroxisomes | 0 | 0 | 0 | 0 | 0 | 0 | – | 0 | 0 | 0 | 0 | 0 | 0 | 0 | 0 |
| SpindlePole | 0 | 0 | 0 | 0 | 0 | 0 | – | 0 | 0 | 0 | 0 | 0 | 0 | 0 | 0 |
| Vacuole | 0 | 0 | 0 | 0 | 0 | 0 | – | 0 | 0 | 0 | 0 | 0 | 2.6 | 2.2 | 2.2 |
External localization resources
Images






























Protein Concentration and Protein Localization Data
| R1 | R2 | R3 | ||||||||||||||||
|---|---|---|---|---|---|---|---|---|---|---|---|---|---|---|---|---|---|---|
| G1 Pre-START | G1 Post-START | S/G2 | Metaphase | Anaphase | Telophase | G1 Pre-START | G1 Post-START | S/G2 | Metaphase | Anaphase | Telophase | G1 Pre-START | G1 Post-START | S/G2 | Metaphase | Anaphase | Telophase | |
| Concentration | -0.3567 | -0.7194 | -0.5876 | -0.5172 | -0.4657 | -0.288 | 0.5467 | -0.0005 | 0.0718 | 0.3618 | 0.287 | 0.4991 | 0.4247 | -0.3365 | -0.2262 | 0.5064 | 0.561 | 0.2619 |
| Actin | 0.0128 | 0.0004 | 0.0099 | 0.0032 | 0.0536 | 0.0015 | 0.0233 | 0.0023 | 0.0108 | 0.0024 | 0.0134 | 0.0079 | 0.0154 | 0.0003 | 0.0063 | 0.0004 | 0.0025 | 0.0053 |
| Bud | 0.0025 | 0.0073 | 0.003 | 0.0003 | 0.0171 | 0.0103 | 0.0095 | 0.0276 | 0.0055 | 0.015 | 0.0112 | 0.0158 | 0.0101 | 0.0102 | 0.0101 | 0.0148 | 0.0054 | 0.0178 |
| Bud Neck | 0.0106 | 0.0005 | 0.0008 | 0.0003 | 0.0014 | 0.0224 | 0.0047 | 0.0008 | 0.0019 | 0.0049 | 0.0021 | 0.0246 | 0.0038 | 0.0007 | 0.0008 | 0.0021 | 0.0025 | 0.0137 |
| Bud Periphery | 0.0026 | 0.0046 | 0.0036 | 0.0003 | 0.0192 | 0.0113 | 0.0104 | 0.0097 | 0.007 | 0.0155 | 0.0098 | 0.0218 | 0.0096 | 0.0049 | 0.0068 | 0.0165 | 0.0105 | 0.0156 |
| Bud Site | 0.0154 | 0.0133 | 0.0011 | 0.0007 | 0.0067 | 0.0052 | 0.0258 | 0.0381 | 0.0195 | 0.0116 | 0.0077 | 0.0064 | 0.0164 | 0.0217 | 0.013 | 0.0016 | 0.0023 | 0.0059 |
| Cell Periphery | 0.0008 | 0.0004 | 0.0002 | 0.0001 | 0.0004 | 0.0005 | 0.0017 | 0.0009 | 0.0006 | 0.0006 | 0.0005 | 0.0005 | 0.0008 | 0.0005 | 0.0005 | 0.0003 | 0.0003 | 0.0005 |
| Cytoplasm | 0.1613 | 0.2042 | 0.1786 | 0.5007 | 0.3142 | 0.1436 | 0.3299 | 0.2288 | 0.3229 | 0.4922 | 0.5348 | 0.2557 | 0.2446 | 0.1917 | 0.223 | 0.4634 | 0.3969 | 0.1767 |
| Cytoplasmic Foci | 0.0208 | 0.0085 | 0.0266 | 0.0235 | 0.0182 | 0.0096 | 0.0252 | 0.0079 | 0.0232 | 0.0221 | 0.0374 | 0.0098 | 0.016 | 0.0105 | 0.0064 | 0.0143 | 0.0118 | 0.0066 |
| Eisosomes | 0.0004 | 0.0001 | 0.0002 | 0 | 0.0009 | 0.0001 | 0.002 | 0.0002 | 0.0004 | 0.0001 | 0.0001 | 0.0001 | 0.0002 | 0.0001 | 0.0001 | 0 | 0.0003 | 0.0001 |
| Endoplasmic Reticulum | 0.0061 | 0.0021 | 0.0037 | 0.0089 | 0.0043 | 0.0019 | 0.0043 | 0.0019 | 0.0029 | 0.0035 | 0.0032 | 0.0019 | 0.0069 | 0.0014 | 0.0019 | 0.0018 | 0.0052 | 0.0018 |
| Endosome | 0.0104 | 0.0019 | 0.0097 | 0.0141 | 0.0465 | 0.0031 | 0.0142 | 0.002 | 0.009 | 0.0234 | 0.0242 | 0.0037 | 0.0131 | 0.0019 | 0.0023 | 0.0066 | 0.0201 | 0.0034 |
| Golgi | 0.0039 | 0.0002 | 0.0031 | 0.0063 | 0.0195 | 0.0004 | 0.0057 | 0.0003 | 0.0025 | 0.001 | 0.0043 | 0.0014 | 0.0031 | 0.0002 | 0.0014 | 0.0003 | 0.0057 | 0.0004 |
| Lipid Particles | 0.0188 | 0.0003 | 0.0068 | 0.0095 | 0.0358 | 0.0017 | 0.0106 | 0.0006 | 0.0066 | 0.0012 | 0.0049 | 0.0005 | 0.0058 | 0.0005 | 0.0005 | 0.0001 | 0.0118 | 0.0004 |
| Mitochondria | 0.0016 | 0.0007 | 0.001 | 0.0499 | 0.0166 | 0.0011 | 0.0074 | 0.0007 | 0.0105 | 0.0013 | 0.0012 | 0.0015 | 0.0027 | 0.0006 | 0.0008 | 0.0004 | 0.0039 | 0.0015 |
| None | 0.6038 | 0.7192 | 0.7265 | 0.3306 | 0.3398 | 0.3378 | 0.3914 | 0.5997 | 0.5424 | 0.3293 | 0.2893 | 0.2297 | 0.5035 | 0.7009 | 0.685 | 0.4266 | 0.3677 | 0.3281 |
| Nuclear Periphery | 0.0097 | 0.0011 | 0.0025 | 0.0057 | 0.007 | 0.0054 | 0.0053 | 0.0041 | 0.0018 | 0.0048 | 0.0036 | 0.0068 | 0.0152 | 0.0013 | 0.0026 | 0.0014 | 0.0294 | 0.0081 |
| Nucleolus | 0.0042 | 0.0033 | 0.0012 | 0.0003 | 0.0016 | 0.038 | 0.0081 | 0.0044 | 0.0026 | 0.0056 | 0.0018 | 0.0391 | 0.0066 | 0.0029 | 0.0025 | 0.0049 | 0.0106 | 0.0306 |
| Nucleus | 0.0938 | 0.0267 | 0.0051 | 0.0033 | 0.0222 | 0.3647 | 0.0938 | 0.0519 | 0.0125 | 0.0269 | 0.0268 | 0.3363 | 0.099 | 0.0425 | 0.0253 | 0.0334 | 0.0868 | 0.3403 |
| Peroxisomes | 0.006 | 0.0002 | 0.0061 | 0.0363 | 0.0646 | 0.0018 | 0.0101 | 0.0007 | 0.0077 | 0.0022 | 0.0038 | 0.0025 | 0.0046 | 0.0004 | 0.0005 | 0.0004 | 0.0051 | 0.0007 |
| Punctate Nuclear | 0.0103 | 0.0018 | 0.008 | 0.0012 | 0.0039 | 0.0334 | 0.008 | 0.0136 | 0.0047 | 0.0274 | 0.0138 | 0.03 | 0.0159 | 0.004 | 0.0071 | 0.0051 | 0.0114 | 0.038 |
| Vacuole | 0.0033 | 0.0029 | 0.0021 | 0.0038 | 0.0047 | 0.0054 | 0.0077 | 0.0036 | 0.0043 | 0.0082 | 0.0053 | 0.0035 | 0.0054 | 0.0025 | 0.0026 | 0.0048 | 0.0073 | 0.004 |
| Vacuole Periphery | 0.0009 | 0.0003 | 0.0004 | 0.0008 | 0.002 | 0.0007 | 0.0011 | 0.0004 | 0.0007 | 0.001 | 0.0008 | 0.0006 | 0.0013 | 0.0002 | 0.0004 | 0.0006 | 0.0024 | 0.0007 |
Sequencing Data
| R1 | R2 | |||||||||
|---|---|---|---|---|---|---|---|---|---|---|
| G1 Post-START | S/G2 | Metaphase | Anaphase | Telophase | G1 Post-START | S/G2 | Metaphase | Anaphase | Telophase | |
| Gene Expression | 6.6786 | 19.6166 | 23.1004 | 19.4148 | 6.1851 | 10.966 | 28.1346 | 36.3773 | 21.5711 | 11.489 |
| Translational Efficiency | – | – | – | – | – | – | – | – | – | – |
Hit Data
| Dataset | Hit |
|---|---|
| Protein Concentration | ✔ |
| Protein Localization | ✘ |
| Gene Expression | ✔ |
| Translational Efficiency | – |
Endocytosis
| Temp | Actin Patch (Sac6-tdTomato) | Cortical Patch (Sla1-GFP) | Late Endosome (Snf7-GFP) | Vacuole (Vph1-GFP) |
|---|---|---|---|---|
| 37℃ | ||||
| RT |
Cell Cycle Omics
CYCLoPs (Ace2-GFP)
| Gene / Allele | Actin Patch (Sac6-tdTomato) | Cortical Patch (Sla1-GFP) | Late Endosome (Snf7-GFP) | Vacuole (Sac6-tdTomato) |
|---|
| Gene | Images |
|---|
| Gene | Images |
|---|
Images are not yet available
Images are not yet available